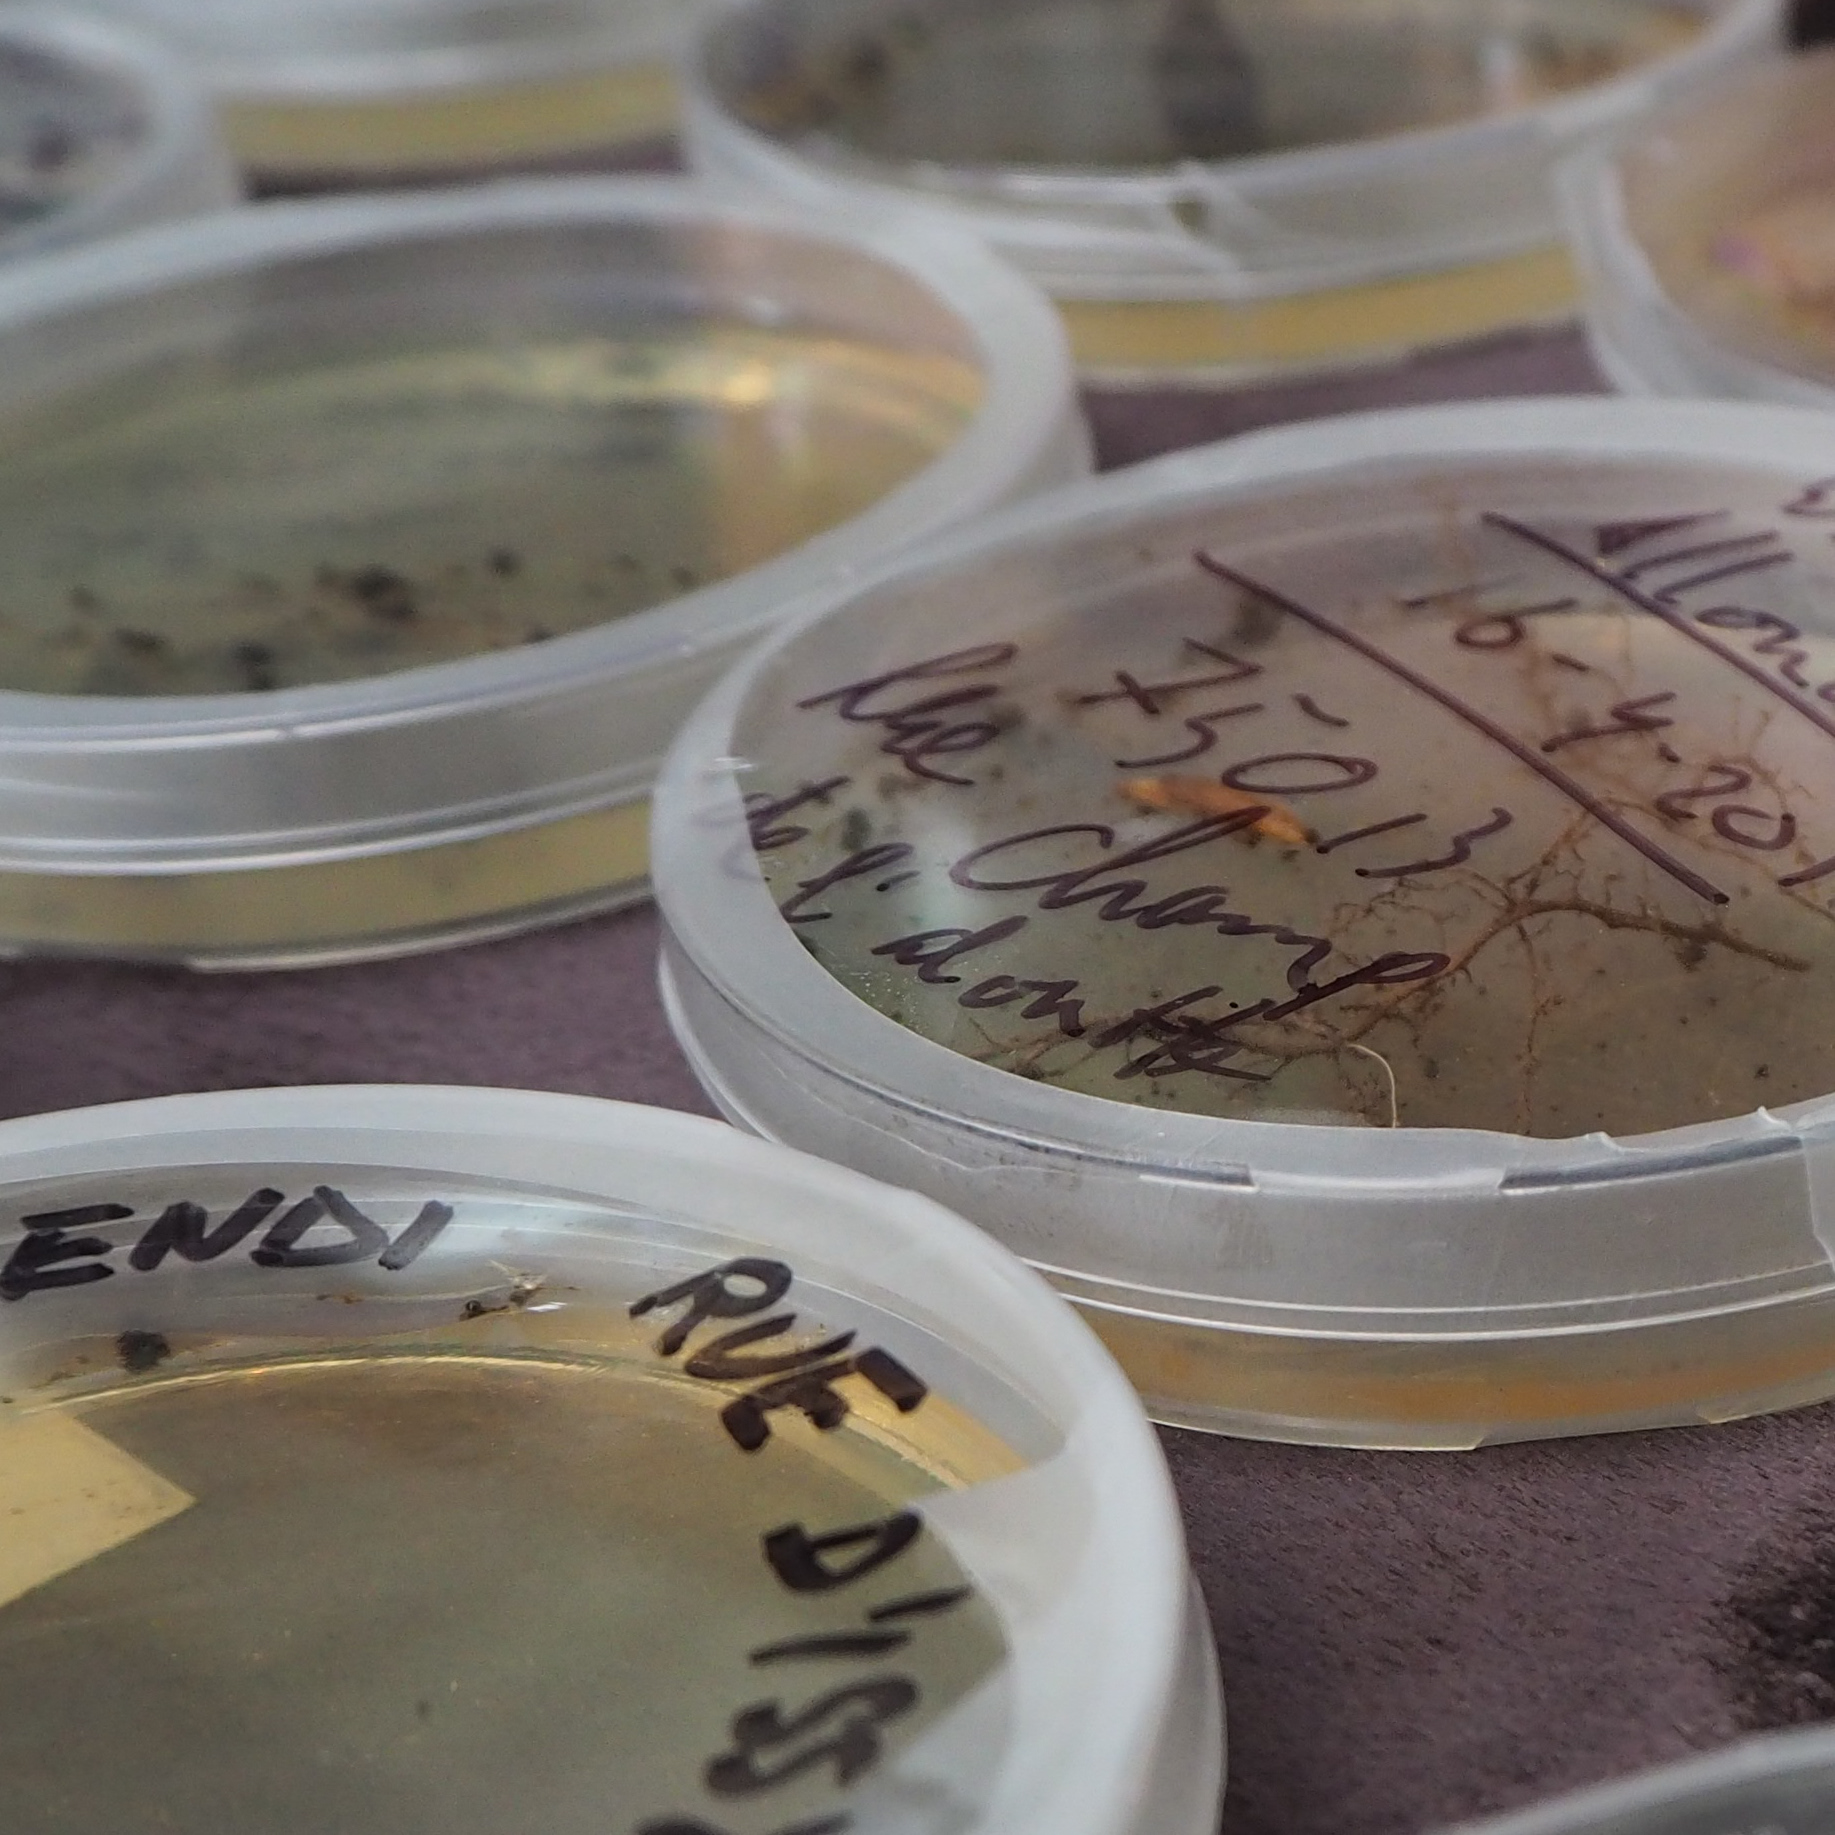

ICSA25 – From Forest to Design Research
2024
Mycelium-based Composites: from Forest to Design Research ICSA 2025 mini-symposium (Antwerp, Belgium. July 8th – 11th, 2025).

DMS24 – From forest to design
2024
This workshop aims to provide a seamless connection between research on innovative mycelium materials and a bioregional, sustainable approach to design, using renewable materials that could be integrated in circular processes.

Entrée
2023
During this workshop, students were introduced to the concept of design terroir. They elaborated on it through to the craft of mycoboscus. This consists of cultivating wood degrading fungi to upcycle a range of local byproducts by fermentation. The result of that? A stunning wood cheese.

Liquid Modelling
2020
Fungal Architectures is a research project which aims at implementing a fungal automaton at the architectural scale. From the speculative context that it offers us, students have been introduced to stochastic modelling workflow to support mycelium-based designs in this workshop.

Marble Breeze
2018
In the context of Tomás Saraceno‘s Carte Blanche exhibition in Palais de Tokyo, and in partnership with Aerocene, thr34d5 organised a free experimental workshop in November 2018. Marble Breeze, or the politics of the troposphere.
Co-lab コラボ series
2016
Co-lab is a scheme for interdisciplinary design workshops conducted by the Open Science School NPO.